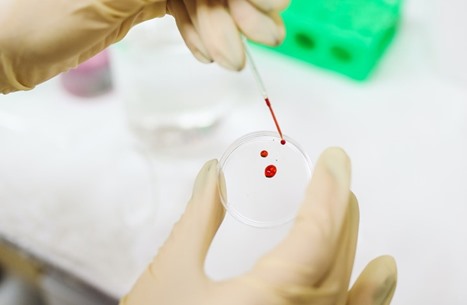
أول تجربة سريرية لنقل دم مصنوع في المختبر للبشر

أجرى فريق من باحثين بريطانيين عملية نقل دم تم تصنيعه في مختبر للبشر في أول تجربة سريرية من نوعها في العالم، بهدف تصنيع فصائل دم حيوية رغم ندرتها.
ويتم اختبار كميات صغيرة – تعادل ملعقتين – لمعرفة كيفية أدائها داخل الجسم، فيما سيبقى الجزء الأكبر من عمليات نقل الدم معتمدا دائمًا على المتبرعين بانتظام.
وتعتبر هذه الفصائل التي يشتغل عليها الباحثون في بريطانيا ضرورية للأشخاص الذين يعتمدون على عمليات نقل الدم المنتظمة، في حالات مثل فقر الدم المنجلي.
وإذا لم يكن الدم مطابقًا تمامًا لطبيعة الجسم، فسيبدأ الجسم في رفضه ويفشل العلاج.
وهذا القدر من مطابقة الأنسجة يتجاوز المستوى المعروف لدى فصائل الدم A و B و AB و o.ونقلت بي بي سي عن البروفيسور آشلي توي، من جامعة بريستول، قوله إن بعض فصائل الدم “نادرة جدًا حقًا” و”قد يكون هناك 10 أشخاص فقط في البلاد” قادرين على التبرع بدم من هذه الفصائل.
وفي الوقت الحالي، لا يوجد سوى ثلاث مجموعات من فصيلة الدم “بومباي” – التي تم تحديدها لأول مرة في الهند – في مخزون بنوك الدم في جميع أنحاء بريطانيا.
يجمع مشروع البحث بين فرق في جامعة بريستول وكامبريدج ولندن ووحدة نقل الدم وزراعة الأعضاء التابعة لهيئة الخدمات الصحية الوطنية البريطانية، ويركز على خلايا الدم الحمراء التي تحمل الأكسجين من الرئتين إلى باقي الجسم.
ويبدأ الأمر بالتبرع العادي بنحو نصف لتر من الدم (حوالي 470 مليلترا)، ثم تُستخدم حبيبات مغناطيسية لاصطياد الخلايا الجذعية المرنة القادرة على أن تصبح خلية دم حمراء، قبل أن يتم تحفيز هذه الخلايا الجذعية على النمو بأعداد كبيرة في المختبرات، ثم يتم توجيهها لتصبح خلايا دم حمراء.
تستغرق هذه العملية حوالي ثلاثة أسابيع، وينتج عن تجمع أولي من حوالي نصف مليون خلية جذعية نحو 50 مليار خلية دم حمراء.
ويتم تصفية هذه الكمية الأخيرة للحصول على حوالي 15 مليار خلية دم حمراء، في المرحلة الصحيحة من التطور للاستزراع.
وقال البروفيسور توي لبي بي سي: “نريد أن نصنع أكبر قدر ممكن من الدم في المستقبل، لذا فإن الرؤية في رأسي هي غرفة مليئة بالآلات التي تنتجه باستمرار من تبرع عادي بالدم”.
وشارك أول شخصين في التجربة، التي تهدف إلى اختبار الدم لدى 10 متطوعين أصحاء على الأقل.
سيحصلان على تبرعين بحجم 5-10 مليلترات بفاصل أربعة أشهر على الأقل – أحدهما من الدم الطبيعي والآخر من الدم المصنوع في المختبر.
وتم تمييز الدم بمادة مشعة، غالبًا ما تستخدم في الجراحات، حتى يتمكن العلماء من معرفة المدة التي سيبقى خلالها في الجسم.
من المأمول أن يكون الدم المصنوع في المختبر أكثر فعالية من الدم الطبيعي.
وتدوم خلايا الدم الحمراء عادة لمدة 120 يومًا تقريبًا قبل أن تحتاج إلى استبدال.
ويحتوي الدم المتبرع به النموذجي على مزيج من خلايا الدم الحمراء الحديثة والقديمة، في حين أن الدم المزروع في المختبر مصنوع حديثًا، لذا يجب أن يستمر لمدة 120 يومًا كاملة.
ويعتقد الباحثون أن هذا قد يسمح بتبرعات دم أصغر وأقل تكرارا في المستقبل.
ومع ذلك، هناك تحديات مالية وتكنولوجية كبيرة أمام هذا المشروع العلمي.
ويكلف متوسط التبرع بالدم هيئة الخدمات الصحية الوطنية في بريطانيا حوالي 130 جنيهًا إسترلينيًا، بينما ستكلف عملية تصنيع الدم أكثر بكثير، على الرغم من أن الفريق لم يحدد المبلغ.
المصدر: عربي 21